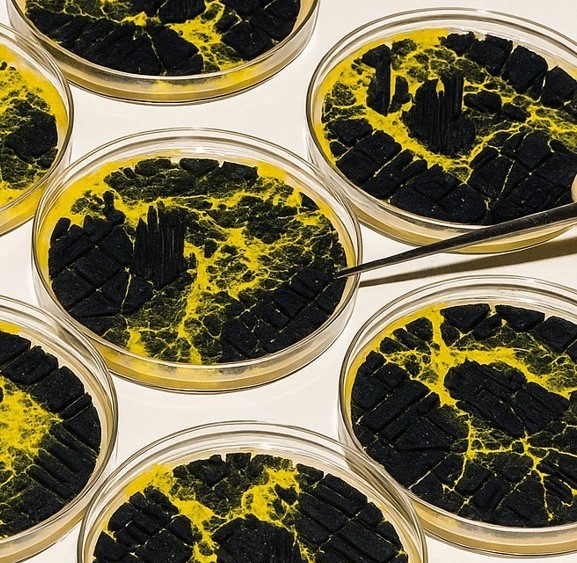

Master in Design for Emergent Futures
Challenge the Way Things Work Today
Become a unique hybrid designer with a focus on emergent design, shaping ideas into impactful interdisciplinary projects grounded in your experiences, passions, and the urgencies that drive you. Move beyond the human perspective and explore new frontiers through hands-on work with AI, digital fabrication, synthetic biology, and more. Build the critical skills to navigate a rapidly changing world while materializing alternative presents.
MDEF 01
First year of the program
Course Length
From October 2026 to June 2027
09 Months – Full Time
Tuition Fees
Non-EU: 15.900€
EU: 13.200€
Spanish: 9.540€
Where?
Fab Lab Barcelona – IAAC & Elisava, Barcelona School of Design and Engineering
Language
English
Edition
8th edition
Credits
60 ECTS
MDEF 02
Second year of the program
Course Length
From October 2026 to June 2028
18 months (09+09) – Full Time
Tuition Fees
Non-EU: 31.800€
EU: 26.400€
Spanish: 15.900€
Where?
Fab Lab Barcelona – IAAC & Elisava, Barcelona School of Design and Engineering
Language
English
Edition
3rd edition
Credits
120 ECTS
Admission Requirements
- Academic Qualifications: A bachelor’s degree that qualifies the candidate to enroll in a master’s programme before the course’s start date. Profiles: Industrial Design, Product Design, Architecture and Urban Design, Graphic Design, Interaction Design, Computer Science, Engineering (Mechanical, Chemical, Product, Material), Sociology, Anthropology, Economy, and related professions.
- English proficiency: All our activities are conducted in English. While an English proficiency certificate is not required, language skills will be assessed during the interview. Applicants may submit a certificate as a supporting document (optional).
Our admissions page provides information on everything you need to know about joining IAAC, from program requirements and the application process to admissions events, information for international students and pre-course opportunities. Dive in to take the first step toward joining IAAC’s innovative community!
Scholarships
Review important information regarding our programme fees, the average cost of living in Barcelona and scholarships opportunities available for eligible applicants.
Presentation
Organised by the Institute for Advanced Architecture of Catalonia – IAAC and ELISAVA Barcelona School of Design and Engineering, in collaboration with Fab Lab Barcelona and the Fab Academy, Master in Design for Emergent Futures integrates theory and practice in a multidisciplinary approach. It pushes design beyond aesthetics to tackle complex systemic challenges with a multiscalar and hands-on methodology.
The programme is built on four pillars—Explore, Build, Reflect, and Apply—guiding students in developing a strategic vision and flexible skill set for uncertain futures. It culminates in a design intervention that addresses hyperlocal needs in Barcelona while engaging with global trends. Graduates apply their expertise across a wide range of fields, from governance and new materials to sustainable food systems.
Master in Design for Emergent Futures offers advanced instruction in digital fabrication through collaborative courses with Fab Academy, led by Neil Gershenfeld of MIT’s Center for Bits and Atoms. Fab Academy is grounded in the MIT rapid prototyping course, MAS 863: How to Make (Almost) Anything, providing students with a unique, hands-on learning experience and access to cutting-edge tools through a distributed educational model.
Why Emergent Design is more important than ever?
We are living in a moment of rapid transition, where today’s challenges demand new ways of thinking and creating.The Master in Design for Emergent Futures prepares you to design for a world that is different from the one we have known. In a localised yet hyper-connected context, you will gain the skills to address complexity, uncertainty, and possibility, and rapid change.
By combining speculative approaches with hands-on practice, emergent design empowers you to prototype meaningful solutions and shape innovative futures. The actions you take today will define the possibilities of tomorrow.
Academic Structure
Master in Design for Emergent Futures (One-Year)
The Master in Design for Emergent Futures is organized into three terms: Oct-Dec, Jan-Mar, Apr-Jun. Each term includes design studios, workshops, seminars, exhibitions, activations and expert masterclasses. The master also offers a research trip, previous trips have been to Shenzhen (China), Cuba, Mallorca, El Hierro (Canary Islands), French Pyrenees and Italian Alps.
Design Studio sessions are central to the program. They guide students through a structured, three-term journey of research, design, and development, where individual interests evolve into advanced projects with clear intervention strategies and roadmaps. Students ground their practice by engaging in situated research, embodied criticism, and first-person experimentation to define areas of intervention. Activities such as mapping, prototyping, and collective reflection interlink personal development with collaborative design spaces. Through iterative testing, critical positioning, and engagement with diverse communities, students cultivate the skills, knowledge, and attitudes needed to design for alternative presents.
Seminars and Workshops delve into specific domains of knowledge and are delivered by relevant expert practitioners and scholars. Throughout the academic year, international experts from the fields of design and emergent technologies, including Artificial Intelligence, Synthetic Biology, Blockchain, Digital Fabrication and Physical Computing, contribute to the program as guest lecturers. Complementing these sessions, exhibitions and activations such as Design Dialogues, the WIP Exhibition, and MDEFest create public platforms for exchange, reflection, and engagement.
The program provides advanced digital fabrication instruction through an adapted version of the Fab Academy (MDEF01) and collaborative classes together with Fab Academy Barcelona students (MDEF02). Fab Academy is directed by Neil Gershenfeld of MIT’s Center For Bits and Atoms and based on MIT’s rapid prototyping course, MAS 863: How to Make (Almost) Anything. The adapted and collaborative classes offer MDEF students with a unique, hands-on curriculum and access to technological tools and resources based on a distributed educational model.
The program has four conceptual pillars:
Explore
Students are exposed to a diverse range of emerging technologies—including artificial intelligence, digital fabrication, biodesign, blockchain, and interaction design—and sociocultural phenomena such as post-growth movements, circular economies, collective intelligence, community-led innovation, and climate activism, all of which have the capacity to disrupt our present understanding of society, industry, and the economy.
Build
Students learn a modular set of maker skills and tools and how these can be used in the design process to translate their ideas into prototypes and prototypes into products. Skills include coding, digital fabrication, hardware design, and computational thinking.
Reflect
Students engage in individual and group reflections to refine their design identity and skills. They critically question the norms and systems shaping contemporary practice. This process fosters responsibility, awareness, and social engagement as designers.
Apply
Students create emergent design responses to explore their curiosities through innovation. They are encouraged to be creative and follow a culture of making where prototyping acts as a generator of knowledge and experimentation is crucial for problem solving.
Master in Design for Emergent Futures+ Thesis (Two-Year)
The second year of Master in Design for Emergent Futures focuses on advancing the Thesis Project initiated in the first year. Students refine their research and innovation agendas using an experimental, multiscalar approach, turning their final projects into viable platforms for academic research, business development, or contributions to open-source communities.
At the heart of the second year there’s the Thesis Project Design Workshop, which is composed of three steps each aligned with specific objectives for each quarter: Implement, Validate, Disseminate.
Implement: In the first Thesis Project Design Workshop, students focus on conducting research and establishing the scientific background of their projects. They delve into relevant theories, methodologies, and frameworks to inform their design process. Students gain a solid understanding of the context and theoretical foundations of their projects.
Validate: In the second Design Workshop, students shift their focus to situating their projects within a specific community and context. They explore the social, cultural, environmental, political, and economical aspects that influence the development and implementation of their designs. Students gain insights into the needs, aspirations, and challenges of the community they aim to serve.
Disseminate: In the final Design Workshop, students work on the scalability model of their projects. They explore strategies for scaling up their designs to reach a wider audience and have a greater impact. Additionally, students develop sustainability and viability strategies for their projects, considering factors such as funding, partnerships, and distribution to create a comprehensive plan for implementing their designs.
The Thesis Project is complemented by seminars and workshops to support the development of the thesis by deepening in the fields of Research Methodologies, Emergent Technologies and Emerging Economies.
In this modality, students can select elective courses among a great variety of seminars and workshops shared with other second-year students from IAAC masters.
At the end of the second year we hope that the students have developed their projects within the framework of the following guidelines:
Academic orientation
ECTS credits and continuation of the academic career through other Master or Doctorate programs.
Business Orientation
Development of a business structure around a product or service.
Collective Orientation
Implementation of an accessible technological development for open source communities.
Technical skills
Students gain emergent design methodologies alongside technical skills in coding, digital fabrication, and synthetic biology, developing hybrid profiles as emergent design practitioners. The Master in Design for Emergent Futures also encourages students to critically engage with fields like foresight studies, exploring the impact of disruptive technologies such as blockchain, synthetic biology, AI, and digital fabrication on the creation of alternative presents. Students are supported to develop their own skill set, knowledge, and hybrid profile as designers.
Explore the MDEF archive
On the MDEF website you will find all the detailed information for the MDEF program: syllabi, reading lists, schedules, and faculty details, among other resources. Also, you can navigate the students’ personal websites to stay up to their master’s work.
Check the Final Projects Showcase!
Student Profile
This programme is ideal for creative individuals seeking an innovative Master’s degree in Barcelona’s dynamic international environment. It caters to professionals from diverse fields including Industrial Design, Product Design, Urban Design, Communication, Graphic Design, Interaction Design, Computer Science, Engineering, Sociology, UX/UI Design, Multimedia Design, Arts, Anthropology, and Economics.
Hybrid Profile
MDEF is built on an understanding of individual learning and personal development. It welcomes students from various professional backgrounds. The faculty aims to create a structured learning environment for students to apply their own interests and personalities to project-based learning. The Master favours collaboration and ‘human’ skills such as leadership, stakeholder management and teamwork. It is a safe space for students to explore their beliefs and craft their own ‘hybrid profile’ that mixes various sets of technical and human skills and prepares them to be resilient and agile designers to lead the new normal.
Designers
Students who wish to expand their perspective in the design field – taking theoretical arguments into the practical field, transforming ideas into interventions that challenge the current societal status quo.
Makers
Those interested in deeper comprehending and critiquing the potential possibilities of digital fabrication and practical making to become leaders in societal transformation.
Social Innovators
Designers, makers, entrepreneurs who wish to transform ideas around social innovation into practical, real-world solutions through expanding their technical skills and gaining connections to professional networks.
Critical Thinkers
Those who are eager to question established systems and uncover the deeper forces shaping our world. Motivated by curiosity and concern, seeking to transform critique into meaningful action. Interested in navigating complexity, uncertainty, and ambiguity, seeing design as a tool not only for creating solutions but also for reframing problems and challenging the status quo.
Career Paths in Emergent Design
Graduates of the Master in Design for Emergent Futures follow diverse career paths, leveraging a global network of collaborators for opportunities in research, education, entrepreneurship, and consultancy. Many pursue PhDs, launch startups, or join innovation teams to drive systemic change. Alumni apply their expertise across a wide range of fields, from democratic governance and food system futures to synthetic biology, material innovation or amplified intelligences.
The Master aims to connect students to a vast global network of like-minded collaborators and professional opportunities. Students are encouraged to collaborate with industry, government and other professional sectors to develop more impactful projects. Emergent Futures has collaborated with industry leaders such as Jordi Closa, director of Maker Lab Group at Adidas; Nina Gualinga, Amazonian Activist and recipient of the WWF International President’s Youth Award; Axel Meyer, Head of Design at Nokia Technologies; Nacho Martín, Design Director at FJORD; Nadya Peek Assistant professor of Human-Centered Design & Engineering at University of Washington and previously MIT Media Lab.
Faculty
The MDEF program is built by practitioners and thought-leaders from Fab Lab Barcelona, IAAC, Elisava, Barcelona School of Design and Engineering and curates a high-level program of guest faculty.
Program Advisors
Tomas Diez (Fab City Foundation), Oscar Tomico (Design research methodologies, posthuman sustainability, Eindhoven University of Technology), Ron Wakkary (Design research methodologies, posthuman sustainability, Eindhoven University of Technology), Kristina Andersen (Interaction Design, Industrial Design, Wearables, Fashion, Media Art and Design Research, Eindhoven University of Technology), Angella Mackey (Interaction Design, Industrial Design, Wearables, Fashion, Media Art and Design Research, Eindhoven University of Technology), Adria García, (Transition Design, Holon), Markel Cormenzana (Transition Design, Holon), Ramón Sagüesa (Artificial Intelligence, UPC), Thomas Duggan (Materials and generative design, Thomas Duggan Studio), Citlali Hernández (Designer, artist, interaction design, Axolot, Turbulente), Pau Artigas (Artificial Intelligence and Machine Learning, Taller Estampa), Bani Brusadin (Curator, educator and researcher), Ce Quimera (Artist and researcher, WetLab – Hangar), Ruben Pater (Journalism, Activism, and Graphic Design Untold Stories), Ben Ditto (Creative Technologist Ditto Nation), Eric Pan (SEEED Studio CEO), Alessandro Masserdotti (Open Dot), Pedro Pineda (TMDC Co-Founder)
Thomas Thwaites (Maker, designer, researcher), Manel De Aguas (Cyborg artist and transpecies activist), Lorenzo Patuzzo (AKASHA Foundation), Anastasia Pistofidou (Materials and Textiles Strategic Advisor, PhD Candidate at Elisava Research), Mariana Quintero (Digital literacy, embodied cognition), Marta Delatte (Digital communications advisor), Arnau Sala (Visual artist, music), Lara Campos (Material researcher, S-Biotica), Toni Navarro (Philosophy, gender and technology), Toni Llacer (Social science, phylosophy, economics, ELISAVA), Ruben Pater (Journalism, activism, and graphic designer), Merce Rua (Transition Design), Ariel Guersenzvaig (Design Research and Ethics, Elisava) Mette Bak Andersen (Material Design Lab at KEA), Daniel Charny (From Now On) Jose Luis de Vicente (Design Hub Barcelona), Neil Gershenfeld (Center for Bits and Atoms at MIT) Indy Johar (Dark Matter Labs ), James Tooze (Royal College of Arts and Design), Liz Corbin (UCL), Primavera de Filippi (CNRS) and Nadya Peek (Human Centered Design & Engineering, University of Washington), Ethel Baraona (Care Studies, Politics, Architecture), Hibai Arbide (Journalism, Activism, and Politics), Kaye Simmington (Kickstarter)
Partners
FAQ’s
Can I get my company or a study grant to pay for this?
Yes, you can search for national scholarships or private funds that to cover the costs of your studies. You can also find details about scholarships offered through IAAC here. Additionally, Emergent Futures offers extra funding opportunities through Elisava’s Masters’ Scholarships.e
What is the relationship between IAAC, Fab Lab Barcelona, and Elisava in the MDEF program?
The Master in Design for Emergent Futures (MDEF) is co-organized by IAAC—through Fab Lab Barcelona—and Elisava. The master is hosted at Fab Lab Barcelona, IAAC’s design and digital fabrication department, which provides access to cutting-edge technologies, and to the global maker community.
IAAC, specialized in advanced technologies for design, awards the degree through the University of Lleida (UdL).
Elisava, is the co-organizing institution, contributing its strong foundation in design methodology, creativity, and communication. As an Master in Design for Emergent Futures student, you are part of both IAAC and Elisava, sharing facilities, professors, and networks across the two institutions.
I don’t have a degree in Design or Architecture, can I apply anyway?
Yes, IAAC requires a University Bachelor degree as a requirement for issuing the Master Degree. This means that any university bachelor can be accepted. There is also the possibility that you don’t have a University degree. In this case, you can still apply, but if you get selected and finish your Master course, you won’t be getting a Master’s Degree but a Certificate of Achievement.
Then, there is the matter of your background. The master offers a multidisciplinary approach to design and we much appreciate to have students from other experiences that improve and enrich the discussions within the program.
Do I need to know Spanish or Catalan?
All activities at IAAC are in English, so there is no requirement to know Spanish or Catalan for academic reasons.
Can I decide to apply to MDEF02 after completing the MDEF01?
Yes, you can apply to Master in Design for Emergent Futures 01+02 or only to the first year of the Master and, later, decide to continue your studies at IAAC with the second year of the master.Explore the
What if I have never done programming or fabrication before?
Fear not! You will be taught the basics on all machines and programs in the duration of the course in order for you to develop your project. You will have access to some assignments of Fab Academy, which is a specialised course that teaches you the tools, techniques and machines for personal fabrication. In addition, we offer a pre-course for introductory purposes.
What kind of job can I get after doing MDEF?
As a graduate of the Master in Design for Emergent Futures , you and your previous experience will create a hybrid profile which can be applied to many professional scenarios. Previous graduates have gone on to work in biology, education, innovation, biomaterials and more. It may even be that you create your own job! More in the Career Paths section.
Can I bring my own project to develop?
Coming to the Master in Design for Emergent Futures with a project in mind can be helpful, however, when studying the course it is likely to change with new knowledge gained. Do not worry if you do not have a project!
Is there a template for the porfolio?
There is no specific template for the porfolio, the style remains at discretion of the candidate, but it should communicate what are your research interests, the past and actual projects you would like to highlight, extra curricular experiences that are relevant to the master research topics.P
More FAQ’s
Find more Frequently Asked Questions in IAAC web.
Are you ready to change your future?
APPLY NOWAre you curious about this program? Ask away